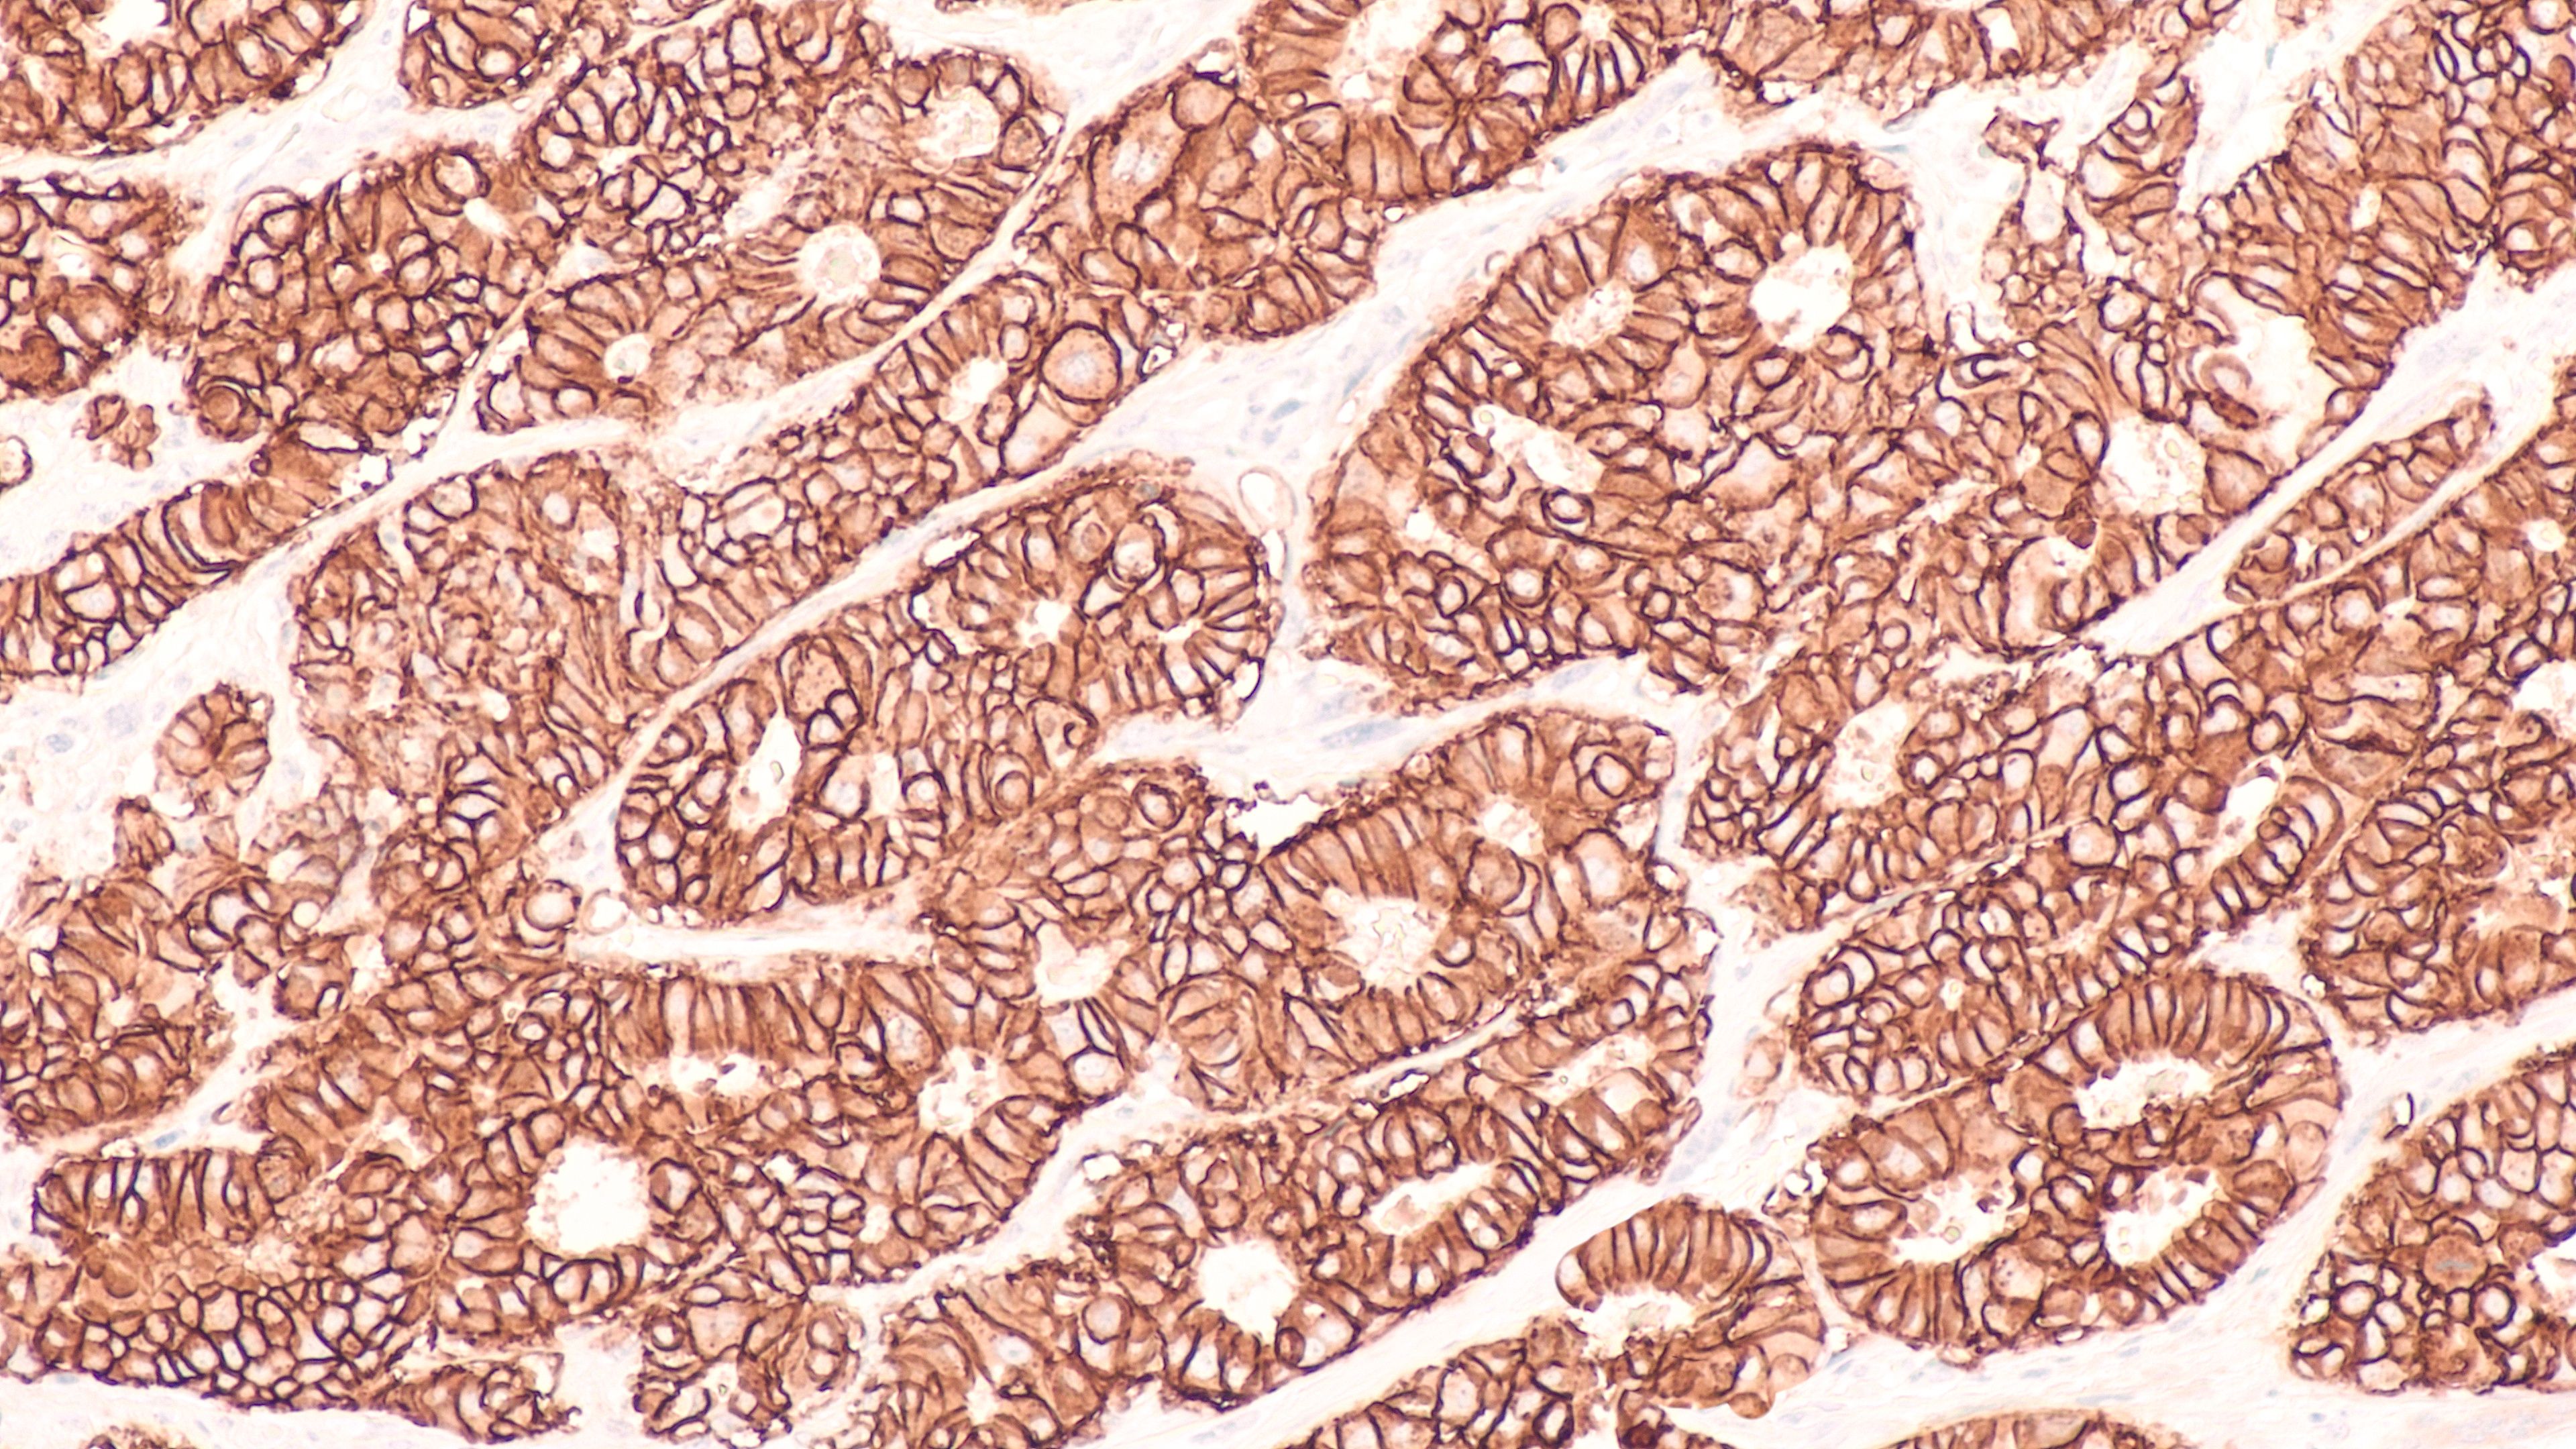

Advances in the Management of HR+/HER2- Ultralow and -Low Metastatic Breast Cancer: New Horizons and Treatment Frontiers
The development of antibody-drug conjugates (ADCs) has transformed the diagnosis and management of hormone receptor–positive (HR+) and HER2-negative (HER2–) metastatic breast cancer (MBC) in recent years. HR and HER2 status should be determined in all …